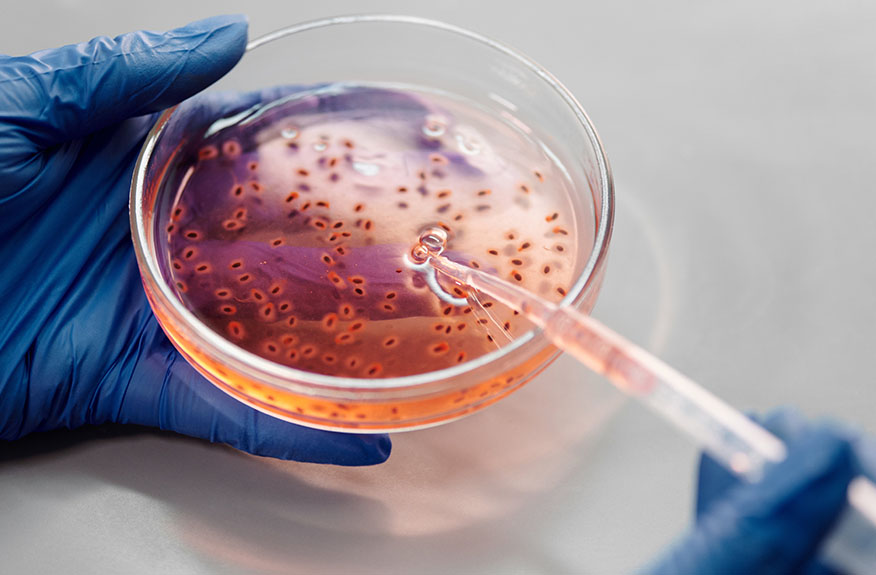

鑫美鑫集团创新技术研究中心科研团队拥有10+位业内资深研发工程师,60+位专业研发精英,研究涵盖皮肤科学、生命科学、表面科学精细化工、应用化学、化学分析、生物学等多个专业领域,搭建四大技术创新平台坚定推进功效护肤产品开发,旨在把化妆品生产研发推向新高度。
教授级研发工程师
业内资深研发团队
产品储备配方

以研究中心为核心,深度整合国内外最前沿的优势资源,与行业链的上下游相关机构建立战略联盟或稳定伙伴关系,实现优势互补,共同为全球各大品牌提供卓越的服务。
技术研发合作:
多个知名高校研究实验室
全球领先原料商:
巴斯夫、赛比克
国际四大香精公司:
德之馨、奇华顿、IFF、芬美意
市场数据分析:
美业研究院数据中心等行业权威数据媒体
行业资源共享:
美业行业信息、前沿研发信息

· 为保证源头品质的优质,鑫美鑫首选全球前十领军供应商原料,成本更高、品质更好,稳定性更强。
· 对工厂资质、原料质检、五证报告、安全测试等方面作出评估,确保鑫美鑫产品的优质稳定。
























